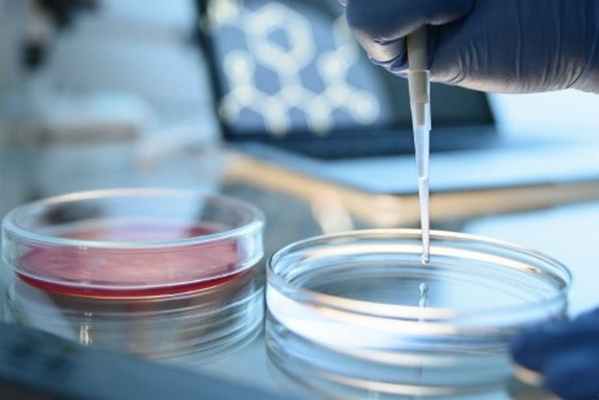

Диагностика лейкозов. Диагностика эритролейкозов.
Добавил пользователь Alex Обновлено: 12.12.2025
Лейкоз под маской ОРВИ у детей. Диагностика в Медицинском центре «Парацельс»
ВНИМАНИЕ: Доступны онлайн-консультации врачей (более 18 специальностей).
Лейкоз (лейкемия, рак крови, белокровие) ー это злокачественное поражение ткани костного мозга, одно из онкологических заболеваний крови. Оно характеризуется появлением большого количества молодых форм лейкоцитов (белых кровяных телец - иммунных клеток) в крови. Лейкоз чаще развивается у детей возрастом 3-5 лет и пожилых людей. Раннюю стадию, острой формы болезни легко спутать с ОРВИ, так как клиническая картина неспецифична.
Маски лейкоза
Дети, заболевшие лейкозом, начинают часто болеть простудными, инфекционными заболеваниями, с признаками интоксикации: боли в суставах и костях, в животе, в горле, в ушах, бывают головные боли.
У ребенка повышается температура, появляется кашель, насморк, он становится вялым, бледным. Это симптомы скрывают лейкоз под «маской» ОРВИ, пневмонии, бронхита, ангины, отита, тонзиллита и даже аппендицита. Так может проявляться острый лейкоз у детей. Инфекция в большинстве случаев сопровождает лейкемию, тем самым надежно прячет ее за собой.
Такие пациенты могут получать лечение в инфекционном отделении, в ЛОР-отделении, у пульмонолога, детского хирурга, невролога, офтальмолога либо амбулаторно проходят лечении под наблюдением участкового педиатра. Такое лечение не приводит к улучшению, а иногда, даже усугубляет течение лейкемии.
По причине “маскировки” лейкоза под другие заболевания и отсутствия явных признаков теряется драгоценное время. Доказано, чем раньше начать лечение лейкоза, тем более высока вероятность его успешности.
Огромная роль в ранней диагностике лейкоза принадлежит родителям. От того насколько родители внимательно следят за здоровьем ребёнка, насколько правильно смогут описать его состояние врачу, зависит в каком направлении будет проводиться предварительное обследование.
Лихорадка длительностью более 5-7 дней без других признаков инфекции ー повод обратится за медицинской помощью и записаться к врачу. Такие проявления, как беспричинная слабость, сонливость, потеря аппетита и апатия также не должны оставаться без внимания врача.
Если ребёнок получает лечение, а должного эффекта нет, стоит проявить онконастороженность - попросить доктора, сделать более широкое обследование, чтобы не упустить время.
Рекомендации родителям:
- своевременно обращайтесь за медицинской помощью;
- внимательно относитесь к здоровью детей - наблюдайте и верно описывайте все симптомы;
- не бойтесь брать ответственность, за жизнь и здоровье своего ребёнка - проявляйте онконастороженность;
- не бойтесь спрашивать и переспрашивать, если не поняли, у доктора всё что касается здоровья ребёнка;
- выполняйте все рекомендации и назначения врача, это может быть жизненно важным.
Лейкоз общие сведения
Лейкозы ー системные злокачественные заболевания крови, при которых происходит неконтролируемое бесконечное деление клеток-предшественников лейкоцитов. Онкология ассоциируется с опухолями, но при лейкозах новообразования, как такового нет - в патологический процесс втягивается весь костный мозг (основной орган кроветворения).
Лейкемии подразделяют на острые и хронические. Это устанавливается не на основании длительности течения заболевания, как при других патологиях, а на основании степени созревания и дифференциации клеток - определяется микроскопией.
Обе формы болезни подразделяют на лимфобластный и миелобластный варианты. В обоих случаях в крови появляются клетки-предшественники, которое в норме есть только в костном мозге. Различия между клетками при лимфо- и миелобластном лейкозах определяются в лаборатории.
Причины лейкоза
Доказано, что неконтролируемое деление клеток костного мозга появляется из-за мутации в их ДНК. Но факторов, которые могут вызывать эти мутации множество, их влияние на развитие лейкоза пока до конца не изучено.
Возможные причины развития лейкемии:
- радиоактивное облучение (полученные дозы радиации во внутриутробном периоде, детстве, перенесенная лучевая терапия других онкологических заболеваний);
- частые контакты ребенка или матери во время беременности с некоторыми химическими агентами (бензол, хлорамбуцил, мелфалан);
- заражение вирусом Т-лимфобластного лейкоза (передается через кровь);
- патологии костного мозга (апластическая анемия, миелодисплазия).
Риск развития лейкемии повышается у близнецов, один из которых заболел лейкозом, и у детей с хромосомными аномалиями (синдромы Дауна, Клайнфельтера, Блума, Вискотта-Олдрича, анемия Фанкони, несовершенный остеогенез).
Симптомы лейкоза
Выделяют такие синдромы (симптомокомплексы) при лейкозах:
- Гиперпластический ー вызван массовым проникновением лейкозных клеток во все органы. Характерен увеличением лимфоузлов, печени, селезенки, появление на коже бугорков ー лейкемидов. Часто развивается стоматит, гингивит.
- Геморрагический ー обусловлен дефицитом тромбоцитов и факторов свертывания крови. Наблюдаются носовые, желудочно-кишечные, легочные, маточные кровотечения, кровоизлияния под кожей, на слизистых оболочках, в суставах.
- Анемический ー связан со снижением уровня эритроцитов в крови. Бледность, слабость, нарушение сна, потеря аппетита, высыпания на коже, язвы в углах рта и на слизистой оболочке.
- Интоксикационный ー длительное повышение температуры тела, ночная потливость, головные боли, боли в мышцах.
- Иммунодефицитный ー вызван тем, что незрелые лейкоциты не выполняют своего прямого назначения (защиты организма от микроорганизмов). Наблюдается присоединение бактериальной инфекции (отиты, синуситы, менингиты, гнойные поражения кожи и т.д.).
Важно: Следует отличать жар при инфекции от температуры при лейкемии. Последняя характеризуется стабильностью (не колеблется), продолжается более 14 дней и не реагирует на лечение антибиотиками и жаропонижающими, симптомы сохраняются.
Диагностика лейкоза
Обследование пациентов начинают с развернутого клинического анализа крови. По этому анализу можно уже поставить предварительный диагноз. При наличии лейкозных клеток в крови проводят микроскопическое исследование костного мозга (образец берут из грудины или подвздошной кости). Диагноз подтверждается при обнаружении более чем 30% бластных клеток в костном мозге.
Для определения тяжести поражения внутренних органов назначают:
- биохимический анализ крови;
- общий анализ мочи;
- коагулограмму;
- рентгенографию органов грудной полости; лимфатических узлов, слюнных желёз, печени, органов брюшной полости и малого таза.
Лейкоз не приговор!
Если ребенку с лейкозом не будет назначена химиотерапия, исход один летальный, в 100% случаев. При раннем начале лечения (до развития нейролейкоза ー инфильтрация бластными клетками головного мозга) показатель пятилетней выживаемости составляет около 70%. Это значит, что у двух третей детей, получивших лечение по международным протоколам, нет рецидива в течение 5 лет после окончания терапии.
Менее благоприятные прогнозы в случае развития лейкоза в возрасте до 2-х лет или после 10 лет. У детей с нейролейкозом процент выживаемости невелик, но все же есть. Химиотерапию назначают всем детям независимо от прогноза.
Диагностика лейкоза в Медицинском центре "Парацельс"
Лечением лейкемий занимается онкогематолог в специализированном гематологическом отделении. Туда дети попадают по направлению педиатра или неонатолога (дети до 1 месяца). Очень важно, чтобы эти специалисты имели онконастороженность и были знакомы с международными рекомендациями по диагностике лейкозов.
Специалисты клиники “Парацельс” работают по принципам доказательной медицины (международным протоколам, составленным на основе клинических испытаний). Это сводит к минимуму вероятность постановки ложного диагноза.
Также в нашем медицинском центре разработаны и применяются Годовые программы наблюдения за детьми. Это всесторонний подход наших детских врачей к наблюдению за состоянием здоровья вашего ребёнка.
Программы включают в себя комплексное обследование ваших детей, а также всю необходимую аппаратную и лабораторную диагностику рекомендованную Министерством Здравоохранения РФ. В рамках программ ваш ребёнок получит качественное медицинское обслуживание с применением высокоточного оборудования экспертного класса.
С заботой о Вашем здоровье, Медицинский центр “Парацельс”
Продолжая пользоваться сайтом, вы соглашаетесь с использованием файлов cookie. Подробнее в Политике конфиденциальности
Диагностика лейкозов. Диагностика эритролейкозов.
Диагностика лейкозов. Диагностика эритролейкозов.
Общее количество лейкоцитов в периферической крови никогда не имеет решающего значения для диагноза. В «фазе преодоления» после агранулоцитоза также может отмечаться лейкоцитоз свыше 100 000. Вместе с тем известно, что многие особо тяжелые случаи лейкоза длительно протекают с суб- или алейкемической картиной крови.
Непосредственное исследование костного мозга с помощью стернальной пункции способствует быстрому выяснению диагноза во многих неясных случаях, особенно при суб- или алейкемических формах лейкозов, когда данные исследования периферической крови трудны для истолкования. В стернальном пунктате обнаруживают гиперплазию костного мозга с наличием всех клеточных форм миелоидного ряда, но с отчетливым сдвигом в сторону незрелых элементов и прежде всего миелоцитов. Большей частью обращает на себя внимание полиморфизм величины клеток.
При остром миелобластическом лейкозе преобладают патологические миелобласты. Положительная реакция на пероксидазу помогает установить принадлежность к миелоидному ряду клеток, с трудом поддающихся классификации. Rohr указывает на то, что в ранних стадиях заболевания количество миелобластов может быть еще не увеличено, из-за чего резко ограничивается диагностическая ценность стернальной пункции. Во многих случаях картина костного мозга при миелозе не отличима от реактивных изменений стернального пунктата, наблюдаемых при инфекциях (Heilmeyer).
Иногда более ценные данные, чем исследование пунктата костного мозга, дает изучение пунктата селезенки, в котором вследствие миелоидной метаплазии обнаруживаются все клетки миелоидного ряда в различных стадиях созревания.

Из других клинических проявлений миелоидного лейкоза необходимо остановиться еще на следующих моментах, представляющих дифференциально-диагностический интерес.
Увеличенные лимфатические узлы всегда подозрительны на миелоз: они могут достигать огромного распространения, но при миелоидном лейкозе могут и отсутствовать на всем протяжении болезни. При лимфатическом лейкозе лимфатические узлы обычно вовлекаются чаще, но иногда они поразительно мало увеличены.
Изредка на первый план выступают поражения слизистой оболочки глотки (Epipharynxtumorl). Чаще — особенно при острых формах — поражаются нёбные миндалины (Некротическая ангина). Нередко первыми клиническими симптомами миелоза бывают явления геморрагического диатеза; они особенно резко выступают при остром миелозе. В клинической картине первоначально может преобладать анемия. У пожилых больных лейкоз может маскироваться симптомами сердечной недостаточности, часто наблюдаются экссудативные плевриты, реже — экссудативный перикардит, которые не сразу распознаются как проявления лейкоза.
При наличии болей в костях всегда необходимо исследовать кровь. Во многих случаях заболевание начинается с общих симптомов инфекционного страдания — повышение температуры, потеря веса, разбитость, поты и т. п., в результате чего возникают самые разнообразные ошибочные диагностические предположения. У других больных первыми проявлениями болезни бывают абдоминальные симптомы, как-то: рвота, поносы (водянистые, а часто и кровянистые), вздутие живота.
Всегда подозрительны на лейкоз неясные опухоли костей (хлорома), в особенности костей черепа.
Иногда в качестве раннего симптома лейкоза наблюдается приапизм.
При эритролейкозах происходит разрастание не только эритропоэтических, но и миелоидных элементов. Преобладание миелоидных и эритробластических элементов может быть установлено как в костном мозгу, так и в селезенке. В периферической крови наряду с незрелыми клетками миелоидного ряда отмечается обилие нормобластов. Решающее значение для диагноза имеет исследование стернального пунктата, обнаруживающее повышение эритропоэза с патологическими эритробластами. При чистом лейкозе, например, эритропоэз в костном мозгу уменьшен.
Но между миелоидными лейкозом, эритролейкозом, хроническим эритробластозом (Гейльмейер — Шёнер) и острым эритробластозом (Гульельмо) имеются постепенные переходы.
Информация на сайте подлежит консультации лечащим врачом и не заменяет очной консультации с ним.
См. подробнее в пользовательском соглашении.
Гематология. ОСТРЫЕ ЛЕЙКОЗЫ: КЛАССИФИКАЦИЯ, ДИАГНОСТИКА И ЛЕЧЕНИЕ
Для цитирования: Нурмухаметова Е. Гематология. ОСТРЫЕ ЛЕЙКОЗЫ: КЛАССИФИКАЦИЯ, ДИАГНОСТИКА И ЛЕЧЕНИЕ. РМЖ. 1997;18:9.
Острый лейкоз - заболевание, в основе которого лежит образование клона злокачественных (бластных) клеток, имеющих общую клетку-предшественницу. Бласты инфильтрируют костный мозг, вытесняя постепенно нормальные гемопоэтические клетки, что приводит к резкому угнетению кроветворения. Для многих типов лейкозов характерна также бластная инфильтрация внутренних органов.
Острый лейкоз подразделяют на лимфобластный (ОЛЛ) и миелобластный (ОМЛ). Считается, что возникновение острого лейкоза могут обусловить следующие факторы:
- неустановленные (чаще всего);
- наследственные:
- синдром Дауна
- синдром Блума
- анемия Фанкони
- атаксия-телеангиэктазия
- синдром Клайнфелтера
- несовершенный остеогенез
- синдром Вискотта - Олдрича
- лейкоз у близнецов
- химические:
- бензол
- алкилирующие агенты (хлорамбуцил, мельфалан)
- радиоактивное облучение
- предрасполагающие гематологические расстройства (миелодисплазия, апластическая анемия)
- вирусы HTLV-I, вызывающие Т-клеточный лейкоз и лимфому у взрослых.
В последние десятилетия достигнуты значительные успехи в лечении острых лейкозов. Пятилетняя выживаемость зависит от типа лейкоза и возраста пациентов:
- ОЛЛ у детей - 65 - 75%;
- ОЛЛ у взрослых - 20 - 35%;
- ОМЛ у пациентов моложе 55 лет - 40 - 60%;
- ОМЛ у пациентов старше 55 лет - 20%.
Классификация
Различия между ОЛЛ и ОМЛ базируются на морфологических, цитохимических и иммунологических особенностях названных типов лейкозов. Точное определение типа лейкоза имеет первостепенное значение для терапии и прогноза.
Как ОЛЛ, так и ОМЛ в свою очередь подразделяются на несколько вариантов согласно FAB- классификации (French-American-British). Так, существуют три варианта ОЛЛ - L1, L2, L3 и семь вариантов ОМЛ:
- М0 - недифференцированный ОМЛ;
- М1 - миелобластный лейкоз без созревания клеток;
- М2 - миелобластный лейкоз с неполным созреванием клеток;
- М3 - промиелоцитарный лейкоз;
- М4 - миеломоноцитарный лейкоз;
- М5 - монобластный лейкоз;
- М6 - эритролейкоз;
- М7 - мегакариобластный лейкоз.
В соответствии с экспрессируемыми антигенами ОЛЛ делится на Т-клеточный и В-клеточный типы, включающие в себя в зависимости от степени зрелости несколько подтипов (пре-Т-клеточный, Т-клеточный, ранний пре-В-клеточный, пре-В-клеточный, В-клеточный). Четкая корреляция между морфологическими и иммунофенотипическими вариантами отсутствует, за исключением того, что морфология L3 характерна для В-клеточного лейкоза.
Что касается ОМЛ, иммунофенотипирование (т.е. определение экспрессируемых антигенов) не всегда помогает различить варианты М0 - М5. С этой целью дополнительно используют специальное цитохимическое окрашивание. Для постановки диагноза эритролейкоза (М6) и мегакариобластного лейкоза (М7) бывает достаточно иммунофенотипирования.
Распространенность
ОЛЛ наиболее часто возникает в возрасте 2 - 10 лет (пик в 3 - 4 года), затем распространенность заболевания снижается, однако после 40 лет отмечается повторный подъем. ОЛЛ составляет около 85% лейкозов, встречающихся у детей. ОМЛ, напротив, наиболее часто встречается у взрослых, причем частота его увеличивается с возрастом.
Клинические проявления
Клинические проявления при лейкозах обусловлены бластной инфильтрацией костного мозга и внутренних органов. Анемия проявляется бледностью, вялостью, одышкой. Нейтропения приводит к различным инфекционным осложнениям. Основные проявления тромбоцитопении - спонтанное образование гематом, кровотечения из носа, матки, мест инъекций, десен. Характерны также боли в костях, лимфаденопатия, гепатоспленомегалия. Возможны затруднение дыхания в связи с наличием медиастинальных масс, увеличение яичек, менингеальные симптомы. При ОМЛ встречается гипертрофия десен.
Обследование пациентов
Общий анализ крови: возможно снижение уровня гемоглобина и числа тромбоцитов; содержание лейкоцитов - от менее 1,0 • 10 9 /л до 200 • 10 9 /л, дифференцировка их нарушена, присутствуют бласты.
Коагулограмма может быть изменена, особенно при промиелоцитарном лейкозе, когда в бластных клетках имеются гранулы, содержащие прокоагулянты.
Биохимический анализ крови при высоком лейкоцитозе может свидетельствовать о почечной недостаточности.
Рентгенограмма органов грудной клетки позволяет выявить медиастинальные массы, которые встречаются у 70% больных с Т-клеточным лейкозом.
Костномозговая пункция: гиперклеточность с преобладанием бластов.
Иммунофенотипирование - определяющий метод в разграничении ОЛЛ и ОМЛ.
Цитогенетические и молекулярные исследования позволяют выявлять хромосомные аномалии, например филадельфийскую хромосому (продукт транслокации части 9-й хромосомы на 22-ю; определяет плохой прогноз при ОЛЛ).
Люмбальная пункция используется для выявления поражения центральной нервной системы (нейролейкоз).
Все пациенты с подозреваемым или установленным лейкозом должны быть как можно быстрее направлены для обследования и лечения в специализированные стационары.
Поддерживающая терапия предусматривает трансфузии тромбоцитов, эритроцитов, свежезамороженной плазмы, антибиотикотерапию инфекционных осложнений.
Цель химиотерапии - индукция ремиссии (менее 5% бластов в костном мозге) и последующая элиминация резидуальных бластных клеток посредством консолидирующей терапии. Химиопрепараты нарушают способность злокачественных клеток к делению, а комбинирование двух или трех препаратов повышает эффективность терапии и снижает риск развития резистентности бластов к терапии. Для профилактики и лечения нейролейкоза используются эндолюмбальные введения метотрексата и краниальное облучение.
Трансплантация костного мозга (ТКМ). Аллогенная ТКМ может применяться в случае плохого прогноза при ОЛЛ, при ОМЛ в первую ремиссию, при рецидивах лейкозов. Однако в связи с дефицитом совместимых доноров эта возможность доступна далеко не всем пациентам.
Факторы,обусловливающие плохой прогноз при острых лейкозах, представлены в таблице.
Токсичность терапии
Ранняя токсичность включает тошноту, рвоту, мукозиты, выпадение волос, нейропатии, печеночную и почечную недостаточность, выраженное угнетение кроветворения.
Поздняя токсичность может проявляться поражениями различных органов:
- сердце - аритмии, кардиомиопатии;
- легкие - фиброз;
- эндокринная система - задержка роста, гипотиреоидизм, бесплодие;
- почки - снижение гломерулярной фильтрации;
- психика - эмоциональные и интеллектуальные нарушения;
- вторичные опухоли;
- катаракта.
Все пациенты с острым лейкозом должны наблюдаться не менее 10 лет по завершении лечения. Особого внимания требуют к себе такие проблемы, как задержка роста и эндокринные дисфункции у детей.
Liesner RJ, Goldstone AH. The acute leukaemias. BMJ 1997;314:733-6.
Контент доступен под лицензией Creative Commons «Attribution» («Атрибуция») 4.0 Всемирная.
Диагностика и лечение острых лейкозов и лимфом

Отдел лабораторной медицины МРНЦ им. А.Ф. Цыба располагает уникальной возможностью сделать полноценную иммуно-морфоцитохимическую диагностику острого лейкоза и лимфомы

Высокотехнологичные лабораторные исследования
Качество и точность
От диагностики - к лечению
Талон на ВМП, ОМС
Иммуно-морфоцитохимическое определение варианта заболевания – главный этап при постановке диагноза острого лейкоза или лимфомы. Сочетание иммунофенотипирования и полного морфо-цитохимического исследования является золотым стандартом в диагностике данных локализаций
Диагностика острого лейкоза
Острый лейкоз может развиваться очень стремительно.
Важно, чтобы в кратчайшие сроки были проведены все диагностические мероприятия по установлению варианта заболевания. Определение варианта острого лейкоза необходимо для выбора лечения, применения правильных схем химиотерапии и позволяет избежать фатальных последствий в дальнейшем. Ошибка в диагнозе может быть неисправима. Полноценный диагноз острого лейкоза - это диагноз комплексный при участии морфологов, иммунологов, цитологов, генетиков и клиницистов на основании комплекса! данных морфо-цитохимических и иммунологических и цитогенетических исследований, правильной трактовки морфологической картины костного мозга в четком сопоставлении с картиной крови.
В Отделе лабораторной медицины МРНЦ имени А.Ф. Цыба осуществляется полноценная морфо-цитохимическая и иммунологическая диагностика варианта острого лейкоза в строгом соответствии с рекомендациями Всемирной Организации Здравоохранения и в рамках Европейских диагностических протоколов. Для постановки диагноза необходимо исследование костного мозга! (а не периферической крови). Возможны ситуации, когда получение достаточного для диагностики количества костного мозга невозможно, тогда параллельно исследуется и костный мозг, и периферическая кровь. Пунктат костного мозга, взятый из грудины или костей таза помещается в пробирку-вакутейнер, обработанную К2ЭДТА и отправляется в лабораторию. Опытные лаборанты из одной пробы приготовят препараты для морфо-цитохимического исследования и иммунофенотипирования. Совокупный анализ иммунофенотипирования и полного морфо-цитохимического исследования позволить наиболее точно установить вариант болезни и в кратчайшие сроки назначить соответствующее лечение. Широкая диагностическая панель позволяет выявить индивидуальные особенности иммунофенотипа бластных клеток и использовать эти критерии для оценки минимальной остаточной болезни в процессе терапии. Морфо-цитохимические препараты и данные иммунофенотипирования хранятся без ограничения срока, что позволяет пересматривать их при необходимости.
Диагностика Лимфомы
Лимфома – собирательное определение целого ряда опухолевых заболеваний кроветворной и лимфоидной систем. В соответствии с рекомендациями Всемирной организации здравоохранения (ВОЗ) сейчас выделяют более 50 различных подтипов таких заболеваний и каждое из них имеет свои четкие отличительные признаки. Выявляются эти признаки по данным морфологического, гистологического и иммунологического исследований. Если по результатам этих исследований ясности в диагнозе нет, то врач назначит биопсию лимфатических узлов с проведением иммуногистохимического анализа и дополнительные цитогенетические исследования. В Отделе лекарственной медицины МРНЦ имени А.Ф. Цыба осуществляется полноценная иммунологическая диагностика варианта лимфомы в строгом соответствии с рекомендациями Всемирной Организации Здравоохранения и Европейских диагностических протоколов. Диагностирование лимфомы - это комплексный сложный многокомпонентный анализ с участием морфологов, цитологов и иммунологов, специалистов по проточной цитометрии.
Для правильного диагноза необходимо исследование образцов периферической крови, костного мозга (как пунктата так и материала трепанобиосии) и биопсийного материла лимфоузлов. Однако в ряде случаев для правильной постановки диагноза бывает достаточно иммуно-морфологического исследования периферической крови или пунктата костного мозга. На диагностическом этапе оцениваются критерии, необходимые для определения минимальной остаточной болезни. Данное исследование осуществляет отдел лабораторной медицины МРНЦ им. А.Ф. Цыба. Для этого исследуемый материал помещается в пробирку-вакутейнер, обработанную К2ЭДТА и отправляется в лабораторию.
В лаборатории в данной пробе будет выполнено исследование клеточного состава материала, оценена морфология клеток и выполнено иммунофенотипическое исследование. Данный комплекс методик позволит четко и быстро определить наличие и тип лимфопролиферативного заболевания и в короткие сроки начать правильную терапию.

В сложных диагностических случаях острого лейкоза и лимфомы проводится консилиум с участием ведущих специалистов России и зарубежья (Германия, Австрия, Англия). При необходимости проводится консультация врачей-онкогематологов МРНЦ им. А.Ф. Цыба

Минимальная остаточная болезнь
Оценка количества остаточных опухолевых клеток в процессе терапии или по окончании лечения является обязательной для принятия решения о дальнейшем лечении или для оценки эффективности проведенного лечения. В отделе лабораторной медицины МРНЦ им. А.Ф. Цыба. на основании индивидуальных особенностей иммунофенотипа опухоли, полученных при первичной диагностике, проводится иммунологическая оценка количества клеток минимальной остаточной болезни с использованием методов многоцветной проточной цитометрии. Данное исследование необходимо (является стандартом) и оправдано в процессе терапии острых лимфобластных лейкозов у детей и взрослых больных. В этом случае оценивается пунктат костного мозга.
Также оценка минимальной остаточной болезни, как критерий эффективности терапии проводится при В-клеточном хроническом лимфолейкозе и ряде других В-клеточных лимфом. В этом случае анализируются клетки крови.
Данные исследования осуществляет отдел лабораторной медицины МРНЦ им. А.Ф. Цыба. Для этого исследуемый материал помещается в пробирку-вакутейнер, обработанную К2ЭДТА и отправляется в лабораторию. Иммунологическая оценка количества клеток МОБ проводится только в совокупности с морфологической характеристикой клеток образца.
Лечение лимфом и острых лейкозов
Лечение всех форм лимфом и острых лейкозов осуществляется в Отделении лучевой и лекарственной терапии гемобластозов МРНЦ имени А.Ф. Цыба. Отделение уникально тем, что в нём применяется одновременно комбинированный подход в лечении пациентов, которым диагностирована лимфома, острый лейкоз и другие заболевания кроветворной системы. Химиотерапия и лучевая терапия применяемая в условиях одного подразделения клиники, способствует гибкому использованию возможностей обоих методов, позволяет избегать нежелательных и порою опасных отсрочек лечения. В отделении применяются собственные, выверенные годами, программы персонализированной терапии лимфомы и острых лейкозов с добавлением таргетных препаратов и моноклональных антител.
Использование риск-адаптированных режимов лечения (интенсивность лечения зависит от прогноза заболевания, определяемого по специальной системе баллов), позволяет избежать неоправданного усиления лечения там, где этого не требуется. Специалисты отделения адресно используют стандарты лечения. Не все пациенты способны перенести утвержденные режимы терапии. Многолетний опыт, позволяет эффективно осуществлять индивидуализированное лечение в тех случаях, когда имеются серьезные сопутствующие заболевания, осложнен соматический статус и т.п.

Рекомендации пациентам: что надо знать о своей крови!

Если заподозрен Рак
Развитие любого злокачественного процесса (говоря простыми словами рака) всегда сопряжено с присутствием изменений, выявляемых при исследовании периферической крови. Даже если болезнь еще не дала о себе знать, и нет видимых четких внешних признаков, нет болевых ощущений, то в крови обязательно будут присутствовать определенные нарушения. Поэтому регулярное исследование показателей крови целесообразно и необходимо каждому. Какое же исследование необходимо? Начать надо с простого – общего анализа крови: биохимическое исследование, оценка состояния иммунной системы, то есть исследование иммунного статуса или иначе иммунограммы. В настоящий момент сложилось ложное мнение о том, что оценка иммунного статуса – исследование не дающее ничего.
Хорошо известно, что развитие злокачественного новообразования сопровождается снижением или перераспределением показателей и клеточного и гуморального (изменение в составе и качестве определённых иммунологических показателей) иммунитета, поэтому выявление таких изменений может сыграть важную роль при постановке диагноза, причем на самых ранних этапах. Выявленные изменения в иммунограмме – это не еще значит, что у вас рак. Однако необходимо провести дообследование и установить истинные причины нарушений. Очень важна полнота иммунологических исследований (всесторонняя оценка иммунитета) и правильная трактовка данных, это позволит избежать лишних, зачастую ненужных назначений или напротив, заставит провести более углубленную диагностику. Иммунограмма важна, если вам назначена иммунокоррегирующая терапия.
Второе мнение!
Уже давно в современной онкологической практике существует «второе мнение». Если Вам установили неблагоприятный диагноз: Рак, то «второе мнение» следует получить незамедлительно, поскольку от правильности установленного диагноза напрямую зависит выбор лечения, повторный пересмотр стекол на гистологию и иммуногистохимию представляется всегда оправданным. Иногда (хотя и очень редко!) пациенты получают результат, отличающийся от первоначального, тогда это заставляет пойти на пересмотр всей тактики лечения. МРНЦ имени А.Ф. Цыба располагает широким спектром диагностических возможностей для получения второго экспертного мнения от лабораторных исследований – до сложнейших хирургических и эндоскопических процедур.


Вам назначено лечение
Для лечения многих опухолей стандартом является назначение химиотерапии, лучевой терапии или их сочетание. К сожалению, под влиянием лекарственных препаратов и лучевого воздействия разрушаются не только опухолевые клетки, но также сильно страдают и здоровые клетки. Поэтому при постановке диагноза и назначении такого вида терапии, целесообразно подготовиться, тем самым увеличить шансы выздоровления и снизить негативные воздействия. Для подготовки организма к предстоящим процедурам могут быть использованы инфузионные растворы, средства, которые увеличивают метаболическую активность, гепатопротекторы, различные симптоматические препараты. Для поддержки полноценной функции нервной системы и клеток крови возможен прием комплекса аминокислот, возможно назначение адоптивной иммунотерапии.
Очень важным моментом является соблюдение определенной диеты, подходящей именно Вам. Схему подготовки подберёт и назначит ваш лечащий врач и врач аллерголог-иммунолог, поскольку курс химиотерапии рассчитывается строго индивидуально, то и подготовка к нему также должна быть индивидуальной. В МРНЦ имени А.Ф. Цыба квалифицированная консультация врача аллерголога - иммунолога и консультация онколога-иммунолога может быть назначена в поликлиническом отделении, по понедельникам и средам с 13.00 до 18.00 часов.
Маршрут пациента

Ключевые преимущества диагностики и лечения острых лейкозов и лимфом в МРНЦ имени А.Ф. Цыба
- Комплексный подход в лечении острого лейкоза и лимфом
- Одновременная работа врача-иммунолога и морфолога-цитолога
- Опытные лаборанты проведут исследование из одной пробирки до полной установки диагноза
- Более чем 20-летний опыт лабораторной диагностики
- Полноценная цитохимическая панель, многоцветная проточная цитометрия, широкая иммунофенотипическая панель
- Систематизированное хранение всех данных пациента
- Второе мнение (включая зарубежных специалистов)
- Высоко-квалифицированные морфологи и специалисты-эксперты в области иммунологии специализируются на диагностике и лечении опухолей системы крови (острые лейкозы и лимфомы) вне зависимости от возраста больного (взрослые, дети)

Контактная информация
+ 7 (484) 399–31–30 многоканальный телефон – с 08.-20.00, г. Обнинск
КОМПЛЕКС ПО ПРЕДОСТАВЛЕНИЮ МЕСТ ДЛЯ ВРЕМЕННОГО ПРОЖИВАНИЯ
249036, Калужская область, г. Обнинск, ул. Королёва, д. 4
© 2021 — Официальный сайт «НМИЦ радиологии» Минздрава России.
Политика конфиденциальности
Острые лейкозы

Лейкозы острые — это гетерогенная группа опухолевых заболеваний кроветворной системы, которые начинаются в костном мозге и характеризуются накоплением недифференцированных (бластных) клеток и подавлением нормальных ростков кроветворения. Заболеваемость острыми лейкозами — в среднем 3—5 первичных случаев на 100 000 человек в год. Острые лейкозы распространены повсеместно в разных странах, встречаются во всех возрастных группах, но у детей их удельный вес наибольший среди всех гемобластозов. Мужчины и женщины заболевают с равной частотой.
Классификация
Острые лейкозы классифицируют в зависимости от цитохимических и иммунофенотипических особенностей опухолевых клеток, выделяют:
-острые лимфобластные
-острые нелимфобластные лейкозы.
Современная классификация острых лейкозов предложена группой французских, американских и британских гематологов - FAB-классификация.
Предлейкоз — это доклиническая стадия острого лейкоза, при которой ограниченное количество бластов еще не вызывает явных клинических расстройств (МДС - миелодиспластические синдромы).
Клиника
Клиника развернутой стадии острого лейкоза: характерны нарастающая «беспричинная» слабость, недомогание, повышение Т°. Довольно часто геморрагический синдром: кровоточивость слизистых оболочек (десневые, носовые, маточные, кишечные кровотечения), петехиальная сыпь на коже, в первую очередь голеней, реже наблюдается гематурия и еще реже — кровоизлияние в мозг. Геморрагический синдром - нередко самое раннее проявление острого лейкоза.
При острых миеломнобластных лейкозах характерна гиперплазия десен, из-за которой больные часто впервые обращаются к стоматологу. Весьма характерны язвенно-некротические поражения слизистых оболочек ротовой полости (стоматит), глотки (ангина) и кишечника - некротическая энтеропатия, парапроктит и др.. что объясняется снижением уровня гранулоцитов крови. Начальные симптомы некротической энтеропатии - плеск и урчание при пальпации илеоцекальной зоны, кашицеобразный стул, легкое вздутие живота. В крови в большинстве случаев выявляются бластные клетки - уродливые, с деформированными нуклеолами, двухядерные; обычно много митозов. В костном мозге содержание бластов достигает иногда 95-99%. За счет бластов общий лейкоцитоз в крови иногда очень высок, изредка он в норме; известны и лейкопенические варианты дебюта острого лейкоза. При кариологическом исследовании в бластных клетках обнаруживаются хромосомные аномалии необычное число хромосом, аберрации и т.д.). Анемия при остром лейкозе нередко наступает позднее, чем тромбоцитопения и агранулоцитоз, она объясняется как кровотечениями, так и бластозом в костном мозге. Симптомы анемии весьма типичны для острого лейкоза; обычно малокровие носит нормохромный или гипохромный характер.
Первыми проявлениями острого лейкоза может быть также «беспричинный» субфебрилитет, изолированное увеличение лимфоузла, увеличение селезенки, лейкопения, тромбоцитопения, упорные боли в суставах и др. Увеличение лимфоузлов, печени и селезенки в начале развернутой стадии встречается не всегда, но с течением времени развивается у многих больных острым лейкозом. Болезненность костей выявляется лишь при большой массе лейкозных клеток, т.е. в уже запущенных случаях острого лейкоза. Опыт показывает, что даже при высоком бластозе в крови и костном мозге у пациента может сохраняться достаточный уровень гемоглобина, тромбоцитов и нейтрофилов, и общее состояние остается удовлетворительным (пациент даже отказывается от дальнейшего обследования, утверждая, что он чувствует себя нормально). Обычно это наблюдается при остром лимфобластном лейкозе (изменения в крови выявляются при периодическом осмотре, диспансеризации и т.д.). Задача врача в этих случаях — убедить пациента и его родственников в неотложной необходимости обследования. В других случаях даже небольшой бластоз вызывает выраженную слабость, глубокую тромбоцитопению, анемию и гранулоцитопению. что сразу влечет клинические осложнения. При всех вариантах острого лейкоза наблюдаются те или иные нарушения в свертывающей системе крови, вплоть до ДВС-синдрома, особенно при большом содержании бластов, тем более атипичных промиелоцитов в крови.
ДВС-синдром влечет за собой кровоточивость, нередко летальную.
Острый лимфобластный лейкоз
Острый лимфобластный лейкоз (ОЛЛ) - злокачественная опухоль крови, возникающая в результате мутации на уровне клетки-предшественницы лимфопоэза. Этот тип лейкоза является самым частым онкогематологическим заболеванием у детей (они составляют около 85% всех случаев острых лейкозов). У взрослых острый лимфобластный лейкоз наблюдается в 25% случаев всех острых лейкозов. Учашение заболеваемости острыми лимфобластными лейкозами отмечается у детей в возрасте 2—4 года, затем у лиц в возрасте 50—60 лет.
Классификация: на основе светооптических характеристик лейкозных клеток выделяют три основных варианта ОЛЛ: LI, L2 и L3. У детей чаше наблюдается вариант LI, у взрослых - форма L2.
При иммунофенотипировании различают четыре варианта опухоли:
- пре-В-клеточный вариант,
- ранний пре-В-клеточный,
- Т-клеточный (около 15% всех случаев),
- зрелый В-клеточный (весьма редкий).
После уточнения варианта ОЛЛ, применяют наиболее подходящую лечебную схему и оценивают прогноз для жизни. Так, у детей с ранним пре-В-клеточным вариантом ОЛЛ прогноз достоверно лучше; зрелые В-клеточные острые лимфобластные лейкозы менее благоприятны прогностически, особенно у взрослых. Цитогенетические исследования обнаруживают хромосомные аберрации более чем у половины больных острыми лимфобластными лейкозами. Наиболее серьезный риск-фактор - наличие «филадельфийской» хромосомы. У детей с острым лимфобластным лейкозом эта транслокация встречается в 7% случаев, у взрослых — в 30% случаев. Ухудшает прогноз наличие высокого уровня сывороточной лактатдегидрогеназы в момент выявления ОЛЛ. Один из ведущих риск-факторов — это высокий лейкоцитоз. Отметим, что у больных старше 50 лет ремиссии ОЛЛ удается добиться реже, чем у пациентов более молодого возраста.
Клиническая симптоматика при острых лимфобластных лейкозах: в начале заболевания обычно жалоб нет, или они весьма скудные — умеренная слабость и утомляемость, иногда бледность кожных покровов. В развернутой стадии ОЛЛ может наблюдаться лихорадка, геморрагические явления, малокровие и др. Однако анемизация и геморрагический диатез выражены значительно менее, чем при острых нелимфобластных лейкозах. При острых лимфобластных лейкозах увеличение печени наблюдается не всегда. У молодых больных острыми лимфобластными лейкозами возможна умеренная диффузная лимфоаденопатия. Первыми проявлениями острого лейкоза может быть также «беспричинный» субфебрилитет, бледность кожи и слизистых оболочек, кровоточивость десен, обильные менструации, изолированное увеличение лимфоузла, упорные боли в суставах и др. Почти всегда наблюдается слабость, утомляемость, потливость. Нередко отмечаются рецидивирующие ЛОР-инфекции, герпес. Болезненность костей выявляется лишь при большой массе лейкозных клеток, т.е. в уже запущенных случаях острого лейкоза. Даже при высоком бластозе в крови и костном мозге у пациента может сохраняться достаточный уровень гемоглобина, тромбоцитов и нейтрофилов. и общее состояние остается удовлетворительным.
Диагностика: поскольку специфичных симптомов при острых лейкозах не существует, диагноз устанавливают только после морфологического исследования крови и костного мозга. Появление даже единичных бластных клеток в периферической крови (гемограмма) требует безотлагательного исследования костного мозга (стернальная пункция).
Принципы лечения: госпитализация в гематологический стационар.
Химиотерапия, поспешно начатая в амбулаторных условиях, полностью исключает возможность последующего излечения пациента даже в условиях гематологического центра. Не рекомендуется начинать цитостатическое лечение в амбулаторных условиях, иногда однократное введение цитостатиков или глюкокортикостероидов до неузнаваемости меняет клиническую и гематологическую картину, и в дальнейшем не позволяет поставить правильный диагноз.
Лечение острых лейкозов предполагает:
- индукцию ремиссии,
- консолидацию полученной ремиссии,
- поддерживающую терапию,
- а также профилактику нейролейкемии.
Применяют патогенетическое лечение острого лейкоза с целью достижения полной клинико-гематологической ремиссии. В настоящее время общепринят метод интенсивной комбинированной длительной цитостатической терапии острого лейкоза (тотальная терапия).
Нелимфобластные острые лейкозы
Нелимфобластные острые лейкозы - эти варианты лейкозов возникают в результате мутации одной из миелоидных клеток-предшественников. Преобладают среди лейкозов взрослых.
В группе острых миелоидных лейкозов выделяют следующие формы заболевания:
МО-острый миелобластный лейкоз, при котором бластные клетки имеют минимальные признаки дифференцировки;
M1-2—острый миелобластный лейкоз с наличием клеток разной степени зрелости;
МЗ—острый промиелоцитарный лейкоз;
М4- острый миеломонобластный лейкоз;
М5—острый монобластный лейкоз;
М6—острый эритролейкоз;
М7- острый мегакариобластный лейкоз.
Острый миелобластный (ОМЛ) и миеломонобластный лейкозы (ОММЛ) встречаются чаще всего: среди нелимфобластных острых лейкозов взрослых эти формы составляют ок. 80%. Возрастные пики острого миелобластного и миеломонобластного лейкоза наблюдаются в возрасте до 1-2 лет, затем - в 38 лет (ОМЛ) и в 50 лет (ОММЛ). Клиника: характерно острое начало болезни с высокой лихорадкой, некрозами в горле (при глубокой первичной гранулоцитопении); часто бывают боли в костях, малокровие, геморрагические явления, которые обусловлены не только тромбоцитопенией, но и ДВС-синдромом. Наблюдается кровоточивость слизистых оболочек (десневые, носовые, маточные, кишечные кровотечения), петехиальная сыпь на коже, в первую очередь голеней, реже наблюдается гематурия и еще реже — кровоизлияние в мозг. Геморрагический синдром - нередко самое раннее проявление острого нелимфобластного лейкоза. Увеличение селезенки при остром миелобластном и миеломонобластном лейкозе умеренное. Весьма характерны язвенно-некротические поражения слизистых оболочек ротовой полости (стоматит, гиперпластический гингивит с кровоточивостью), глотки (ангина) и кишечника - некротическая энтеропатия, парапроктит и др., что объясняется снижением уровня гранулоцитов крови. Начальные симптомы некротической энтеропатии: плеск и урчание при пальпации илеоцекальной зоны, кашицеобразный стул, легкое вздутие живота, высокая лихорадка. Прогноз: средняя частота первых ремиссий при остром миелобластном и миеломонобластном лейкозах при современной терапии достигает 60%. Продолжительность первой ремиссии превышает 2 года. Онкологическое выздоровление наблюдается у 10% больных всех возрастов.
Редкие формы острых лейкозов
Макрофагальный острый лейкоз - важнейший и постоянный его клинический признак - высокая асептическая лихорадка, иногда с ознобами. Часто наблюдается гепатоспленомегалия. Бластная инфильтрация печени часто осложняется желтухой.
Мегакариобластный острый лейкоз - клиническая картина сходна с другими острыми лейкозами, в крови и костном мозге наряду с недифференцируемыми бластными клетками присутствуют и мегакариобласты.
Миелодиспластические синдромы (МДС) — гетерогенная группа гемопатий, куда входят разнообразные заболевания неодинаковой природы, сопровождающиеся как значительными изменениями костного мозга, так и его функциональными нарушениями, часто трансформирующиеся в высокобластные острые лейкозы. Разнообразные гемопатии, объединенные экспертами ВОЗ в группу под общим названием МДС, имеют общую причину - повреждение клеток на уровне, близком к стволовой кроветворной клетке. В отличие от других гемобластозов, при МДС клеточный апоптоз сохранен или усилен, что и формирует периферическую би/пан/цитопению на фоне гиперплазии костного мозга.
Преобладающим симптомом является малокровие. Часть гемопатий. входящих в этот «сборник», иногда называют предлейкозом. Современные данные показывают, что предлейкоз - это доклиническая стадия острого лейкоза, при которой ограниченное количество бластов еще не вызывает явных клинических расстройств. Гематологическими признаками формирующегося острого лейкоза являются: нарастающая анемия без ретикулоцитоза; «необъяснимые» гранулоцитопении; «беспричинный» моноцитоз без явной гиперплазии костного мозга в трепанате; хронический нерезко выраженный аутоиммунный гемолиз, немногочисленные очаги гиперплазии в трепанате костного мозга (через несколько лет возможна трансформация в острый лейкоз). Варианты МДС отмечаются в основном у лиц пожилого возраста (старше 60 лет). Характерна слабость, потливость, утомляемость, одышка. Умеренное увеличение печени и селезенки наблюдается только при варианте ХММЛ: лимфоузлы как правило в норме. Лейкозы, развившиеся из миелодиспластических синдромов, отличаются меньшей чувствительностью к терапии, чем первичные острые нелимфобластные лейкозы.
Монобластный острый лейкоз наблюдается весьма редко. Клиническая картина этой формы лейкоза напоминает острый миелобластный лейкоз, однако, в этой форме значительнее выражены интоксикация и гипертермия, чаще наблюдаются некротические изменения слизистой оболочки рта и глотки. Весьма характерна лейкемическая инфильтрация десен, ведущая к гипертрофии сосочков («лейкемический гингивит»). Нередко развивается инфильтрация миндалин и десен, а на поздних этапах прогрессии возникают опухолевые пролифераты во всех внутренних органах, лейкемиды кожи и т.д.
Плазмобластный острый лейкоз отмечается во всех возрастах, в т.ч. у молодых лиц и у детей, характерно острое клиническое течение. Наблюдается увеличение лимфоузлов, селезенки, печени. В сыворотке крови выявляется М-градиент - моноклональный иммуноглобулин (парапротеин).
Промиелоцитарный острый лейкоз - довольно редко встречается - не более 7% всех острых лейкозов. Прежде это заболевание отличалось тяжелейшим прогнозом (массивная кровопотеря или геморрагический инсульт уже в первые недели от момента диагностики), а теперь - это одна из наиболее курабельных форм, при которой наблюдается «онкологическое» излечение на фоне дозревания лейкозных бластов до нормальных форм.
Эритромиелоз острый, эритробластный острый лейкоз, болезнь Ди Гульельмо - редкая форма острого лейкоза. В анамнезе больных острым эритромиелозом часто встречается лучевая или химиотерапия; нередко выявляется как вторичный лейкоз у лиц, пролеченных по поводу лимфогранулематоза, миеломной болезни, эритремии.
Читайте также:
